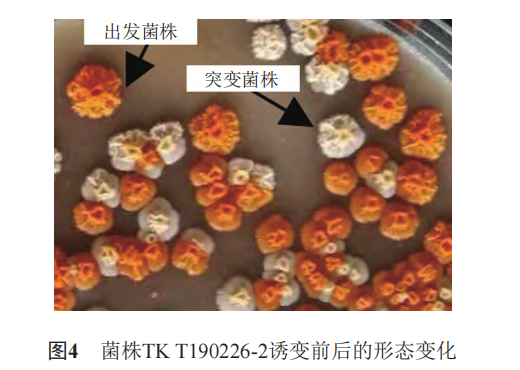

替考拉宁高产菌选育及发酵条件优化
来源: 作者: 发布时间:2022-03-31 15:09 浏览量:34
本期为您推荐河北省工业微生物代谢工程技术研究中心马婕老师研究团队发表在知名期刊《中国抗生素杂志》上的一篇文章:替考拉宁高产菌选育及发酵条件优化。
文章摘要内容如下:
替考拉宁是与临床相关的糖肽类抗生素,由游动放线菌产生,是5个化学结构相似化合物(T-A2-1、T-A2-2、T-A2-3、T-A2-4和T-A2-5)的混合物,其中,T-A2-2是主要有效成分。替考拉宁是治疗成人和婴儿的多重耐药革兰阳性病原体引起的严重感染的一线疗法,同时也是目前为数不多的临床有效活性药物之一,其未来具有广阔的应用前景,但目前存在着产量低等问题限制了应用。微生物产生次级代谢产物的能力主要由微生物的遗传特性决定,遗传特性可以通过诱变来改变。ARTP诱变技术是近年来新兴的一种具有高效率特点的诱变手段,尤其是在微生物菌种改良选育领域。该技术主要是利用高浓度的活性粒子均匀地作用于微生物,从而改变细胞膜或细胞壁的结构并引起基因损伤,诱发生物细胞启动SOS修复机制,最终导致微生物基因序列及其代谢网络发生相应变化。
本研究为获得一株稳定遗传的高产新菌株并提高替考拉宁产量,以替考拉宁产生菌游动放线菌T19为出发菌株,通过常压室温等离子(ARTP)诱变技术,获得一株具有稳定遗传性的高产新菌株,并对转速、接种量、温度和pH等发酵条件进行了优化,确定了最佳的发酵工艺条件,从而提高了替考拉宁的产量。诱变后菌株的发酵效价水平较出发菌株提高了42%;在转速为220 r/min,接种量为7.5%,温度为28℃,pH为6.5时,该菌株发酵效价水平比出发菌株提高了80%。ARTP诱变技术可有效用于游动放线菌的诱变选育,可大幅度提高替考拉宁的产量,为其工业化生产奠定了基础。
文章精彩内容如下: